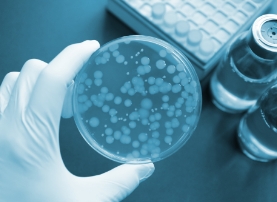

を変える再生医療
を変える再生医療 を活用した再生医療
を活用した再生医療再生医療とは、誰もが持っている自然治癒力=「再生する力」を生かした幹細胞治療です。
今、日本で最も注目されている医療技術です。幹細胞は、骨髄やさい帯血、内臓臓器や脂肪などの中にいますが、 当院では身体への負担が少ないお腹の脂肪を採取しております。
幹細胞を用いた臨床研究では、
回復不能と診断された症状が改善する事例
が多く報告されております。

東京ソフィア再生クリニックは厚生労働省に第二種・第三種再生医療等提供計画を提出し、計画番号を取得した医療機関です。

第二種・第三種再生医療等提供計画承認済み


お支払いいただいた治療費には、その一部が税金から還付される医療費控除制度の対象になる場合があります。
当院では治療費の領収書を発行していますので、大切に保管してください。
